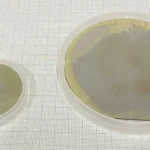

Submitted on behalf of Gigahertz-Optik. Gigahertz-Optik’s UV-C Germicidal Radiometer Kit includes: X1-1-V03 Radiometer UV-3725-4 254nm UV-C Detector UV-37xx-Z01 80° Field of View Adapter BHO-11 Carry Case K-UV3725-S Irradiance Responsivity Calibration in A/(W/m²) and A/(W/cm²) at 254nm with calibration certificate ISO17025 accredited test … [Read more...] about Introducing the UV-C Germicidal Radiometer Kit
Press Release
Introducing Ultravio: Pioneers in Tailor-Made UV Lamps Launch Globally
Press release submitted on behalf of Ultravio. Ultravio, Slough, UK, a company with decades of unrivalled expertise in manufacturing specialised UV disinfection lamps, is proud to announce its global launch. After years of working behind the scenes with a few select OEMs, Ultravio is stepping into the limelight, ready to serve customers worldwide with its superior UV lamp … [Read more...] about Introducing Ultravio: Pioneers in Tailor-Made UV Lamps Launch Globally
The IUVA Requests Abstracts for 2024 IUVA Americas Conference
As new challenges continue to arise in public health, drinking water, reuse water and wastewater treatment, air pollution, hospital infections, ballast water treatment and industrial effluents, new applications emerge for UV technologies. The focus of this conference is to present the recent advancements in technology and research addressing the environmental, health, and … [Read more...] about The IUVA Requests Abstracts for 2024 IUVA Americas Conference
Early Bird Registration Opens for 2024 WateReuse Symposium
Register today at the lowest rate for 2024 WateReuse Symposium being held in Denver, Colorado, on March 11-14. The annual WateReuse Symposium is the premier conference on water recycling — attracting water professionals and water reuse practitioners globally for knowledge-sharing, networking, and collaboration. The event is planned in collaboration with The Water Research … [Read more...] about Early Bird Registration Opens for 2024 WateReuse Symposium
IUVA Announces New President/Officers, Board Members
Press release submitted on behalf IUVA. The International Ultraviolet Association (IUVA) is pleased to announce that Ted Mao, Chief Technology Officer, Evercloak, has assumed the role as President of the group for a two year term. Ernest (Chip) Blatchley, Purdue University, has been named President-Elect; and Jennifer Osgood, with CDM Smith, is now immediate past … [Read more...] about IUVA Announces New President/Officers, Board Members
Nuvonic Introduces the ECO Product Line Boosting Performance and Efficiency in UV Water Treatment Systems
Press release submitted on behalf of Nuvonic. Nuvonic, Slough, United Kingdom, a global UV technology solutions provider, today unveiled its latest offering, the ECO product line for Ultraviolet (UV) water treatment. The ECO is a breakthrough for UV systems in food & beverage, pharmaceuticals & healthcare, semiconductor & microelectronics, power & energy, and … [Read more...] about Nuvonic Introduces the ECO Product Line Boosting Performance and Efficiency in UV Water Treatment Systems
Crystal IS and Asahi Kasei Announce First 4-inch Aluminum Nitride Substrate
Press release submitted on behalf of Crystal IS. Crystal IS, Green Island, New York, an Asahi Kasei company, today announced the successful production of a 4-inch (100 mm) diameter single-crystal aluminum nitride (AlN) substrate. This is the first reported aluminum nitride substrate at this size and demonstrates the scalability of Crystal IS processes for growing AlN bulk … [Read more...] about Crystal IS and Asahi Kasei Announce First 4-inch Aluminum Nitride Substrate
Open-Source Protocols Available for Review and Comment
Press release submitted on behalf of Protocols.io We are excited to share two new resources with the IUVA community. We invite you to comment and peer-review these open-source protocols. These protocols were developed to help standardize collimated beam experiments and improve accessibility for new researchers. The Polychromatic Fluence Response Protocol is based on the … [Read more...] about Open-Source Protocols Available for Review and Comment
Applied UV Announces Operational Efficiencies to Simplify Corporate Structure, Increase Gross Margins, Enhance Profitability and Drive Organic Growth
Press release submitted on behalf of Applied UV NEW YORK, NY -(NewMediaWire) - August 28, 2023 - Applied UV, Inc. (NASDAQ: AUVI), a leader in global food security, air quality, and intelligent building solutions, today announced an organizational restructuring plan intended to improve operational performance and drive shareholder value creation. The Company has initiated a … [Read more...] about Applied UV Announces Operational Efficiencies to Simplify Corporate Structure, Increase Gross Margins, Enhance Profitability and Drive Organic Growth
FDA Grants Xenex Authorization for LightStrike+ UV Robot via De Novo – First & Only Microbial Reduction Robot for Healthcare Facilities
Press release submitted on behalf of Xenex Disinfection Services AN ANTONIO--(BUSINESS WIRE)--The U.S. Food and Drug Administration (“FDA”) has granted Xenex Disinfection Services, Inc. (“Xenex”) De Novo authorization for the company’s LightStrikeTM+ device, a high-intensity, broad-spectrum ultraviolet (UV) light robot. The authorization creates a new medical device product … [Read more...] about FDA Grants Xenex Authorization for LightStrike+ UV Robot via De Novo – First & Only Microbial Reduction Robot for Healthcare Facilities